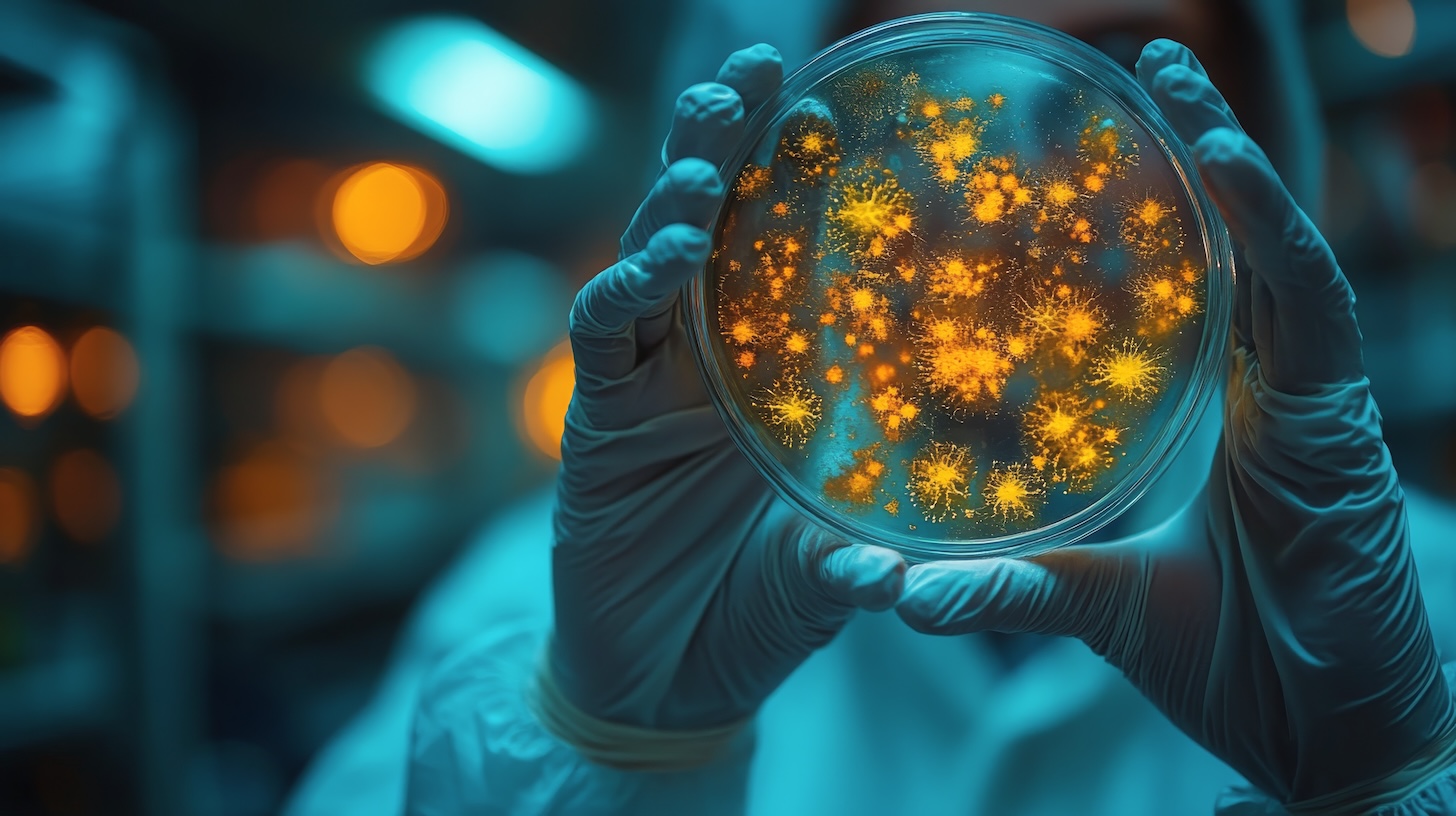
researcher-analyzes-petri-dish-containing-microbial-growth_54416636

Testing Catalog
We help clinicians diagnose diseases by analyzing samples at the microscopic level.
OUR COMPREHENSIVE TESTING CATALOG
We offer a comprehensive range of cutting-edge tests to cater to diverse healthcare needs.
Detect respiratory infections early and guide the right treatment fast.
- Identify viral & bacterial causes
- Includes COVID, RSV, and Flu A/B
- Support for chronic lung issues
- Faster recovery times
Quickly detect and treat urinary tract infections before complications arise.
- Identify bacteria in urine
- Guide antibiotic therapy
- Prevent kidney infections
- Fast & accurate results
Help clinicians diagnose disease by analyzing tissue samples.
- Microscopic tissue analysis
- Cancer detection support
- Inflammation assessment
- Accurate pathology reporting
To uncover allergy triggers and support personalized allergy management.
- Food & environmental testing
- IgE antibody screening
- Identify allergic responses
- Improve quality of life
To provide fast, accurate testing for COVID-19 infection and immunity.
- PCR and antigen testing
- Antibody detection
- Travel clearance support
- Reliable, same-day results
To identify infections and immunity through blood-based antibody testing.
- Antibody and antigen testing
- Autoimmune disease insights
- Track immune responses
- Guide vaccination decisions
To offer precision diagnostics with standalone testing options.
- Custom test selection
- Target specific concerns
- Quick turnaround
- Tailored patient care
We offer streamlined panels for faster decision-making
- Complete health snapshots
- Multi-marker efficiency
- Help detect underlying issues
- Ideal for wellness checks
To identify infections and resistance in bacteria and fungi for humans.
- Detect bacterial pathogens
- Identify fungal infections
- Test for antibiotic resistance
- Optimize treatment plans
To help clinicians diagnose disease by analyzing tissue at microscopic levels.
- Microscopic tissue analysis
- Cancer detection support
- Inflammation assessment
- Accurate pathology reporting
To detect and confirm H. pylori infection with lab accuracy.
- Breath, stool, or blood tests
- Diagnose stomach ulcers
- Prevent chronic gastritis
- Improve gut health
To identify infections and resistance in wounds for faster, targeted healing.
- Detect bacterial pathogens
- Identify fungal infections
- Test for antibiotic resistance
- Optimize treatment plans
To ensure patient safety by detecting harmful substances in the body.
- Drug and substance screening
- Therapeutic monitoring
- Poison detection
- Forensic support
To understand hormonal imbalances and support personalized treatment.
- Reproductive hormone levels
- Adrenal and pituitary checks
- Menopause & fertility support
- Clear, actionable results
To detect and monitor hepatitis infections with precision.
- Identify virus type (A, B, C)
- Monitor liver function
- Track infection progress
- Inform treatment decisions
To aid in early detection and management of cancer.
- Cancer screening support
- Monitor treatment response
- Identify tumor activity
- Improve clinical outcomes
To help manage thyroid health and hormone balance effectively.
- TSH, T3, T4 levels
- Hypo/hyperthyroidism insights
- Monitor treatment progress
- Early detection tools
To diagnose fungal nail infections early and support effective treatment.
- Detect fungal species in nails
- Confirm onychomycosis
- Prevent spread and recurrence
- Support targeted antifungal care
Make An Appointment
Booking a test with Diamed Labs is seamless and convenient. Visit our portal to schedule an appointment that fits your preferences and availability. We make the process hassle-free!